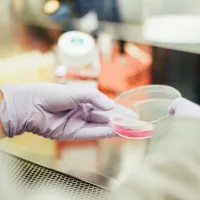
A gloved hand holding a petri dish with a pink solution in a laboratory setting.

Research institutes, centres and groups
-

Active Living
The Active Living research group aims to promote lifelong active living through comprehensive health, rehabilitation, and technological strategies. -

Antibody and Vaccine Group
We are a collaborative group of about 60 scientists and clinician scientists working to a common goal: how to harness the immune system to cure cancer. -

Antibody Drug Development
Our interdisciplinary research generates antibody-based therapeutics for cancer and autoimmunity. -

Biomedical Imaging Unit
We provide research and diagnostic services in high quality, high-resolution light and electron microscopy, specialising in 3D imaging. -
Cancer B-Cell Group
Our research translates new understanding of tumour B-cell biology into clinical practice. -

Centre for Cancer Immunology
The Centre for Cancer Immunology's interdisciplinary research helps scientists and medics to collaborate worldwide. By bringing people together and sharing our expertise, we're working faster than ever before towards a cure for cancer. -

Centre for Developmental Origins of Health and Disease
Our research characterises how the environment during human development contributes to risk of chronic disease, underpinning resilience to challenges in later life. -

Centre for Health Technologies
Our research areas are: Optimizing Treatment and Behaviours; Novel Medical Devices and Systems; Community Health and Wellness; AI and Health. -

Centre for Sudden Death
We research sudden death and traumatic grief, from the moment of loss to years after, working with families to improve care, systems and support when lives are shattered. -

Child and Adolescent Research Group
Our research focuses on the physical and mental health of Children and Adolescents. -

Clean Air Programme
Tackling indoor and outdoor air pollution for a healthier future. -

Clinical Cardiology Research
Our research characterises how the environment during human development contributes to risk of chronic disease, underpinning resilience to challenges in later life. -

Clinical Ethics, Law and Society (CELS)
We bring together interdisciplinary expertise to address ethical, legal and psychosocial issues of implementing new technologies. -

Genetics of Inflammatory Bowel Disease
We aim to help people with inflammatory bowel disease using genetic research and clinical data analysis to personalise diagnoses and treatments. -

Global Health Community of Practice
The Global Health Community of Practice is an open forum to support all members working across Global Health in either Research, Education or Knowledge Exchange, and innovation. -

Health Data Science
-

Human Genetics and Genomic Medicine
Our research is centred around understanding the mechanisms of disease, using contemporary techniques and bioinformatics to identify and understand the basis of human disease and translating this for patient benefit. -

Inclusive research: Learning disabilities and neurodivergence (INCLUDE)
We promote health and quality of life of neurodivergent people and people with learning disabilities. -

Institute for Life Sciences
We bring together interdisciplinary researchers with expertise across the themes of health and medicine, living systems, disruptive life technologies, and insights through data -

Institute of Developmental Sciences
Researching collaboratively to advance health across the life course through research and innovation in the developmental sciences -

Medical Education Research
Our research aims to support teaching and learning activities and inform the student experience. -

MINDS-IC
We investigate the underlying mechanisms, diagnosis, and treatment of disorders characterised by impulsivity and compulsivity. -

National Biofilms Innovation Centre (NBIC)
NBIC is the central hub where academia, industry, government and public policy come together to tackle the grand challenges biofilms present, impacting $4 trillion in global economic activity. -

NiPPeR study
We do detailed assessments of mothers' nutrition and metabolism before and during pregnancy. We are developing new approaches to provide children with the healthiest start in life. -

Paediatrics and Child Health - Clinical and Experimental Sciences
We aim to improve the health of children and the adults that they will become through innovative research and education. -

Precision Biosciences Innovation Hub
We use big data, computational approaches and 'in silico' digital twins of biological systems. Through our research, we gain a detailed understanding of the biological processes needed for sustainable health, environment and food. -

Primary Care Research Centre
We are an internationally renowned centre of excellence known for conducting high-quality research to improve people’s lives. We inform and enhance evidence based primary health care in the UK and around the world. -

Public and Patient Involvement and Engagement
Get involved with medical research in Southampton. -

Southampton Centre for Medical and Health Humanities
Our group explores the intersection of medicine, healthcare practices and the human experience through the lens of the humanities. We provide a platform for teaching innovations, public engagement, research collaborations and grant applications. -

Southampton Clinical Academic Training Scheme (SoCATS)
SoCATS helps to identify aspiring clinical academics and supports them in their training as they work towards becoming the research leaders of the future. -

Southampton Clinical Trials Unit (SCTU)
We deliver world-leading clinical trials of innovative new treatments and diagnostic tools. Our trials directly influence routine clinical practice for the benefit of patients. -

Southampton Health Economics
We aim to produce evidence to help allocate resources in a way that promotes health and effective health care. -

Southampton Health Technology Assessments Centre
We are a leading centre for health technology assessment and health services research in the UK. Our expertise in evidence synthesis, health economics and information science informs timely policy decisions on the use of new healthcare technology and services, directly benefitting patients and ensuring good value for money for our health service. -

Vision Science
Vision Science works with other research institutions to increase the potential of a cure, or improve treatment, for age-related macular degeneration and other blinding eye diseases. -

Web Science Institute
We study the relationship between society and the largest information system in history: the World Wide Web.











